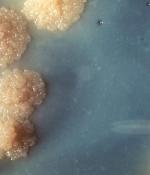

Telengana 
Rice Crop at Risk in India: new frontiers for hopperburn
(0)The brown planthopper can destroy rice crops. Now the pest is seen mostly in the east and south of India. But if the climate changes, the pest may invade other regions in India. Recent research identified the possible extent of expansion of the pest’s habitat. Sanghamitra reports research from Cuttack.
Tuberculosis bacteria in labs: search for a clinically appropriate model
The abundance of food, comfort and safety in culture media have made the strain of tuberculosis bacteria in labs less virulent over generations. Indian scientists from NCR region have now come up with protocol for producing a more clinically relevant laboratory model. Bharati Swamy reports:

Spotted Owlet: Biocontrol Agent in Agriculture
Researchers from the PJTSAU, Hyderabad investigated the dietary preferences of the spotted owlets in and around Rajendranagar. By analysing the pellets of indigestible food regurgitated by the owlet, the researchers demonstrate the value of the bird for farmers. Aparna Kalawate reports:

Transparent Metallic Electrodes: for flexible digital devices
Scientists from NIT Warangal, DMRL Hyderabad, SRM Institute of Science and Technology, and ARCI Hyderabad have now come out with a super thin, transparent and flexible metallic electrode for optoelectronics and wearable digital devices. Read the report here:
Mercury and Methylmercury: detect and discriminate
Mercury in the environment is dangerous to human health. Methyl mercury is even more so. Nilanjan Dey from BITS Pilani, Hyderabad has designed a cost effective and highly sensitive method to detect both.
Detecting Ovarian Cancer
Researchers from IIT Hyderabad and IIT Bombay collaborated to come up with a method to detect ovarian cancer. They attached antibodies against fibronectin, a protein, to porous carbon derived from sweet corn husk to make the biosensor.

Hydrogen from Food Waste: Piloting the process
An estimated seven crore tonnes of food waste is thrown out by Indians every year, polluting the environment. Converting this waste into biohydrogen energy is an economic opportunity, say researchers from CSIR-IICT. Municipalities need to listen to this.
The Wettest Place on Earth: Rainfall Shifts in the North-East
While examining the rainfall data from the North-East, Indian meteorologists discover that the wettest place on the earth has shifted from Cherrapunji to Mawsynram. What could be the reason? Read on.
Wound Healing Dynamics: Cell density and migration
In wound healing, the epithelial cells migrate to close the wound. Researchers from TIFR Hyderabad find that the leader cells in this mass migration emerge depending on density, and the leadership positions shift dynamically, depending on the contours of the wound.
Salinity Tolerant Pearl Millet: Role of MicroRNA
Pearl millet is more tolerant to soil salinity than most other crops. Scientists from ICRISAT Hyderabad along with researchers from other parts of the world have now started uncovering the secrets of the success of survival of the crop under salinity. One more step towards sustainable agriculture under the threat of increasing soil salinity.
